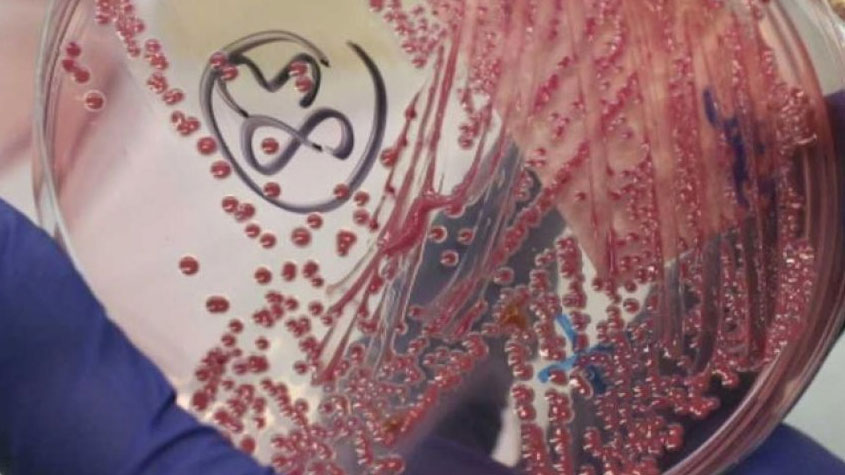

#أمريكا تلغي حظر تمويل دراسات "الميكروبات الخطيرة"

بعد "صاروخ #الرياض".. #أمريكا تدعو لإجراءات ضد #إيران

#ميانمار تحظر دخول مقررة #الأمم_المتحدة لحقوق الإنسان إلى أراضيها!

#الفلبين تعلن وقف إطلاق النار من جانب واحد خلال احتفالات عيد الميلاد

طائرات حربية صينية تحاكي هجوما جويا فوق #بحر_اليابان

#كندا و #أمريكا تعقدان اجتماعا يوم 16 يناير بشأن #كوريا_الشمالية

#كيم_جونغ_أون يعدم مسؤولين اثنين أحدهما وصف بأنه "الرجل الثاني في البلاد"!

الأوروبية #السعودية تندد بمحاكمات إعدام بقضايا مخدرات تفتقد العدالة ويمارس فيها التعذيب

#الكرملين: #الأسد كان ومازال الرئيس الشرعي لـ #سوريا

استطلاع جديد يكشف تدهور شعبية #ترامب بشكل قياسي

#روسيا: قوات الأمن تصفي شخصا فجر قنبلة في مدينة #ستافروبل

#الخارجية_الروسية: يجب حل قضية #القدس من خلال المفاوضات المباشرة






